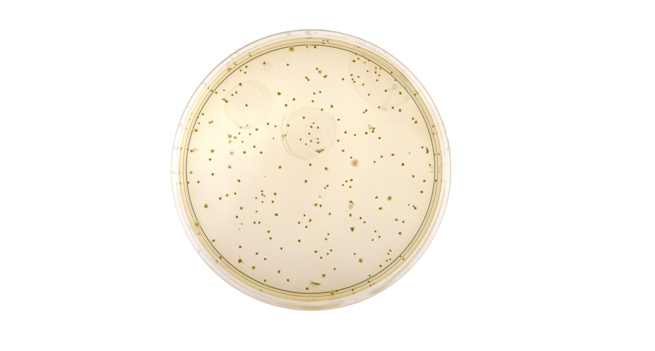
血琼脂基础培养基检验结果的解释

血琼脂培养基

血琼脂基础培养基检验结果的解释
图片尺寸655x351
血琼脂培养基
图片尺寸3872x2592
血琼脂(ba);细菌生长的选择性培养基.
图片尺寸1200x801
血琼脂(ba琼脂)-细菌生长的选择性培养基.
图片尺寸1200x801
yy_t 1167-2009 厌氧血琼脂基础培养基
图片尺寸2811x2108
哥伦比亚血琼脂平板cna血平板专业培养基
图片尺寸600x450
koraba 血琼脂培养基 基础 (化妆品卫生规范系列)250g/瓶
图片尺寸800x800
在血琼脂平板上35℃培养18~24h,形成灰白色,凸起,光滑,湿润,边缘整齐
图片尺寸2592x4608
速发血琼脂培养基营养琼脂平板tcbs弧菌检测r2a/tssa/lb细菌培养
图片尺寸500x500
哥伦比亚血琼脂培养基使用
图片尺寸1080x1080
哥伦比亚血琼脂平板 即用型培养基无菌平板 Ф90mm 10皿/包
图片尺寸800x800
哥伦比亚血琼脂基础培养基 oxoid cm0331b 500g/瓶
图片尺寸800x797
血琼脂培养基营养琼脂平板tcbs弧菌检测re2a/tsa/lb细菌培养基9cm
图片尺寸800x800
pyj琼脂培养基条生物营养平板水产孤菌检测试剂盒tcbs血琼脂平板
图片尺寸1920x1920
普通拟杆菌atcc8482标准模式菌种血琼脂培养基37度厌氧活化二代菌
图片尺寸800x800
血琼脂基础血液琼脂培养基02-202生物试剂br250g/瓶北京奥博星
图片尺寸800x800
血液琼脂 血琼脂培养基基础250g/瓶化学试剂试剂细菌溶血实验检测
图片尺寸800x800
hb0124 哥伦比亚血琼脂基础 250g 血琼脂培养基 营养丰富 可开票 hb
图片尺寸800x800
血琼脂平板营养琼脂平皿lb琼脂血平板检测盒细胞培养基tsa90mm
图片尺寸800x800
血琼脂培养基基础2号 250g hb6230 青岛海博
图片尺寸800x800